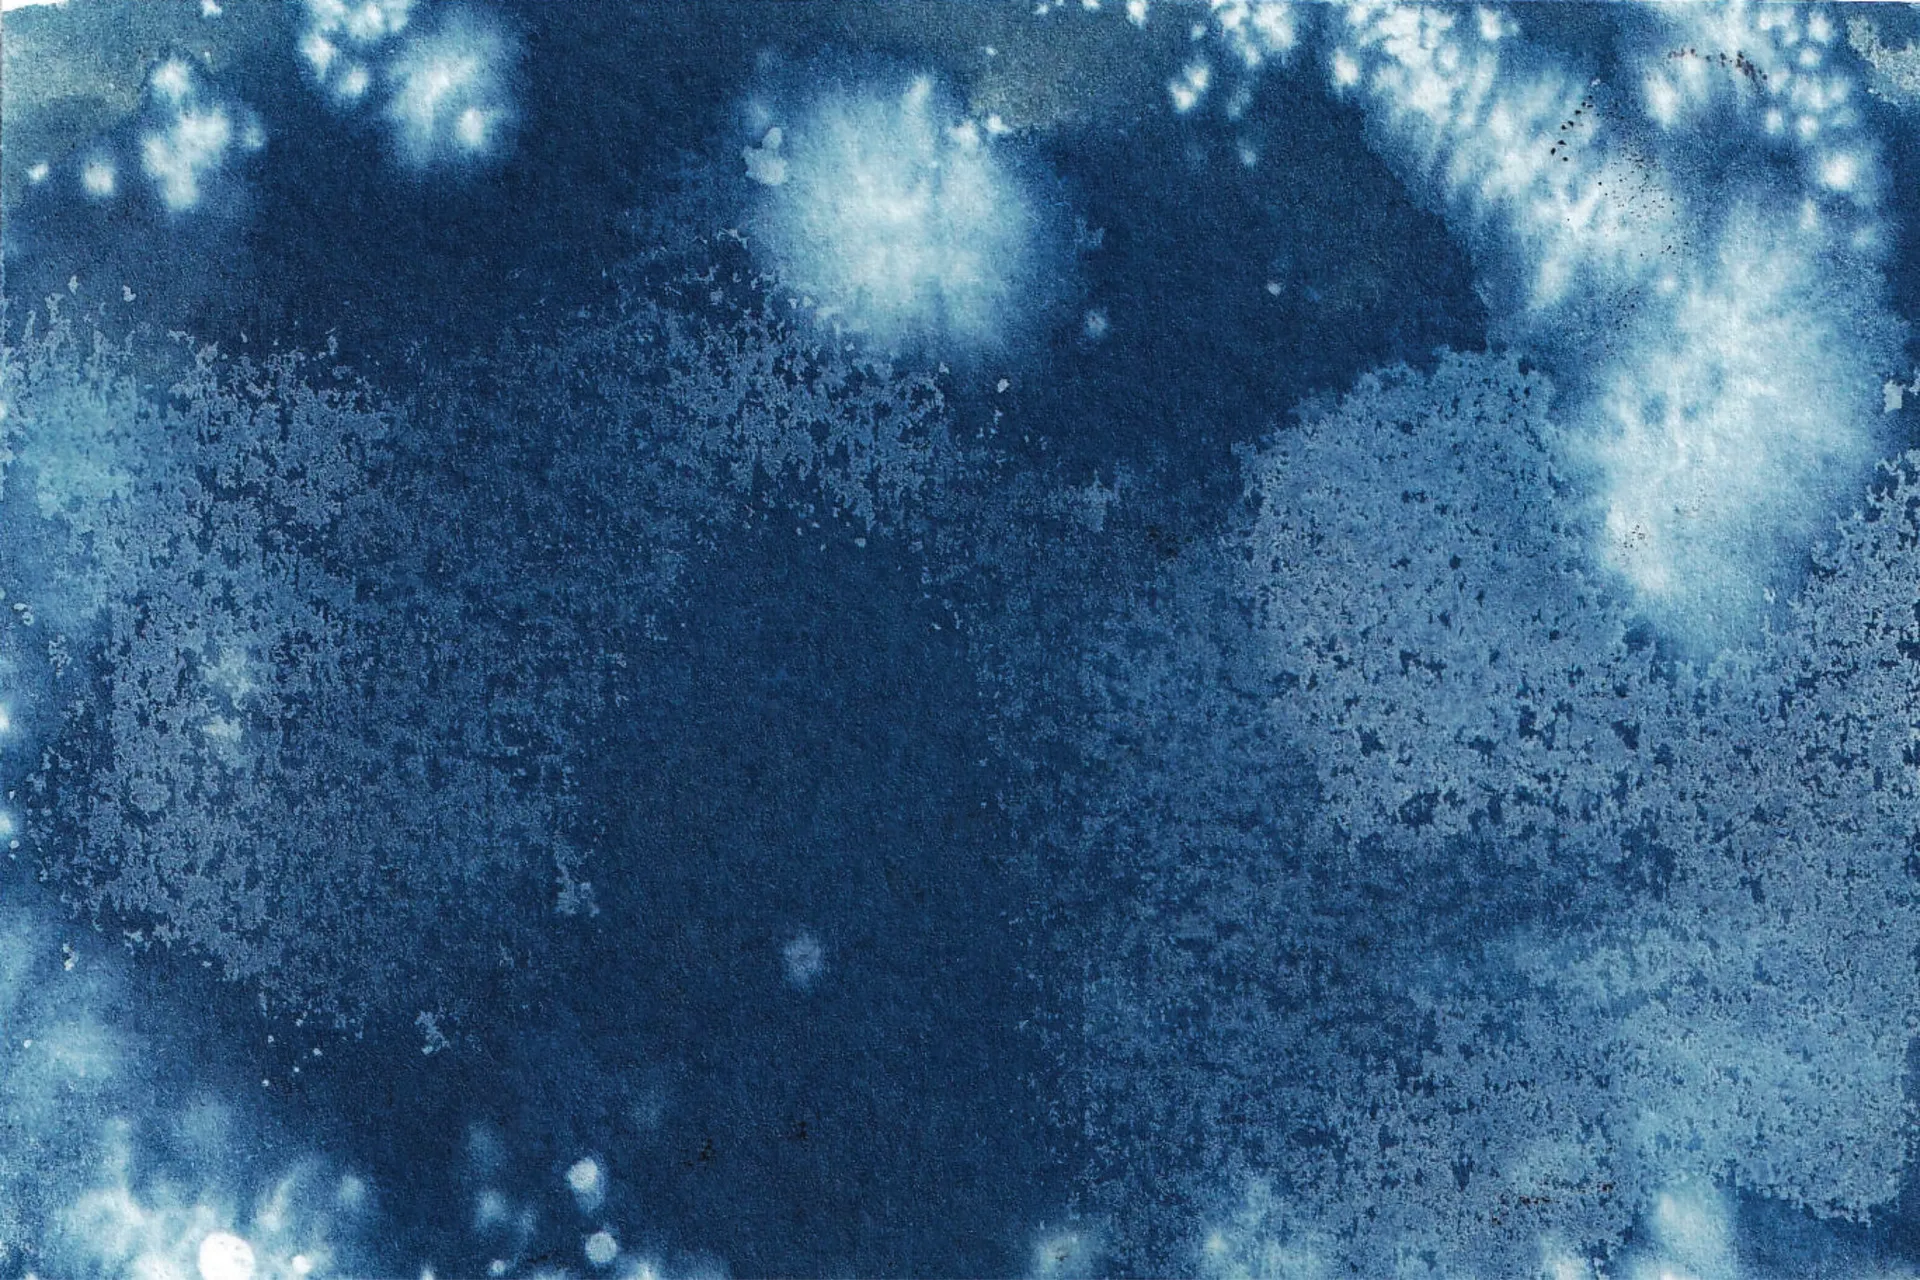

Beth is an experimental artist whose work is often focused on portraying lived experiences through a variety of different mediums with a specific interest in using light and nature to create her work. She enjoys working with a variety of print processes from lino to cyanotype and is interested in film making with a more experimental approach. She likes to create bold work that can evoke emotion and tell a story.
Her graduate film, Grief Stained Blue, is an animation that takes you through a journey of grief. It has been entirely created from cyanotypes and aims to shine a light on the complex emotion of grief and how it evolves as you grow using both abstract and symbolic visuals. Using art as a tool of communication is vital to this project and its goal is to help people understand grief, something that can often be difficult to vocalise. It also aims to open up a conversation about grief.